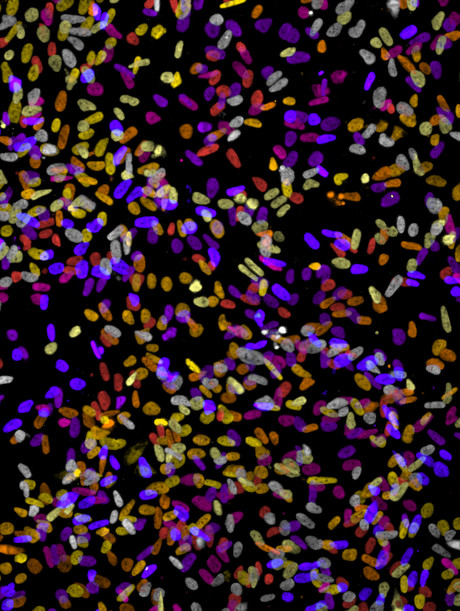
Improved use of existing drugs possible for cancer treatment

Improved use of existing drugs possible for cancer treatment
Researchers have identified a unique feature of cancer stem cells that can be exploited to kill the deadly cells thought to be the reason that cancer comes back after therapy. Understanding this feature will be useful for delivering more targeted cancer therapeutics to the right patients.
The study, undertaken by McMaster University and published in scientific journal Cell Chemical Biology, reveals that an existing set of drugs is effective in killing cancer stem cells and explains how this led the team to uncovering important details about how these cells are working in human tumors.
“The drugs helped us to understand the biology,” said Mick Bhatia, principal investigator of the study and scientific director of the McMaster Stem Cell and Cancer Research Institute. “We’ve worked backwards, employing a series of drugs used in the clinic to understand a new way that cancer stem cells can be killed.”
The researchers found that a particular protein, called Sam68, is an important actor in cancer stem cells, and that this protein allows existing drugs to work on cancer cells, causing them to die.
Bhatia hopes that this information can be used to deliver targeted therapies to the patients who would benefit from them, while sparing others from unhelpful treatments. He believes that treatment of blood cancers like leukaemia and other cancers such as prostate, colon and renal will follow the example set in breast cancer, where patients receive treatments tailored to their specific form of the disease.
“In the case of breast cancer, other researchers have found new ways to make existing drugs more effective by only giving them to people who were likely to benefit based on their specific traits and using drugs that target these traits,” Bhatia said.
He said while developing a new drug takes an average of about 15 years and comes with a price tag in the hundreds of millions, defining the role of existing drugs to use them better in patients will help to accelerate the process of bringing the right drugs to the right people.
Originally published here.
Australia invests further $14.6 million in national allergy research
Further funding until June 2028 for the National Allergy Centre of Excellence (NACE) and the...
Balcony and nearby construction activities linked to RPA deaths
The investigation report into the Royal Prince Alfred Hospital fungal outbreak that occurred in...
$1bn vaccine and antivenom manufacturing facility opens
A $1 billion cell-based influenza vaccine and antivenom manufacturing facility has opened in...




![[New Zealand] Transform from Security Awareness to a Security Culture: A Vital Shift for SMB Healthcare — Webinar](https://d1v1e13ebw3o15.cloudfront.net/data/89856/wfmedia_thumb/..jpg)
![[Australia] Transform from Security Awareness to a Security Culture: A Vital Shift for SMB Healthcare — Webinar](https://d1v1e13ebw3o15.cloudfront.net/data/89855/wfmedia_thumb/..jpg)



